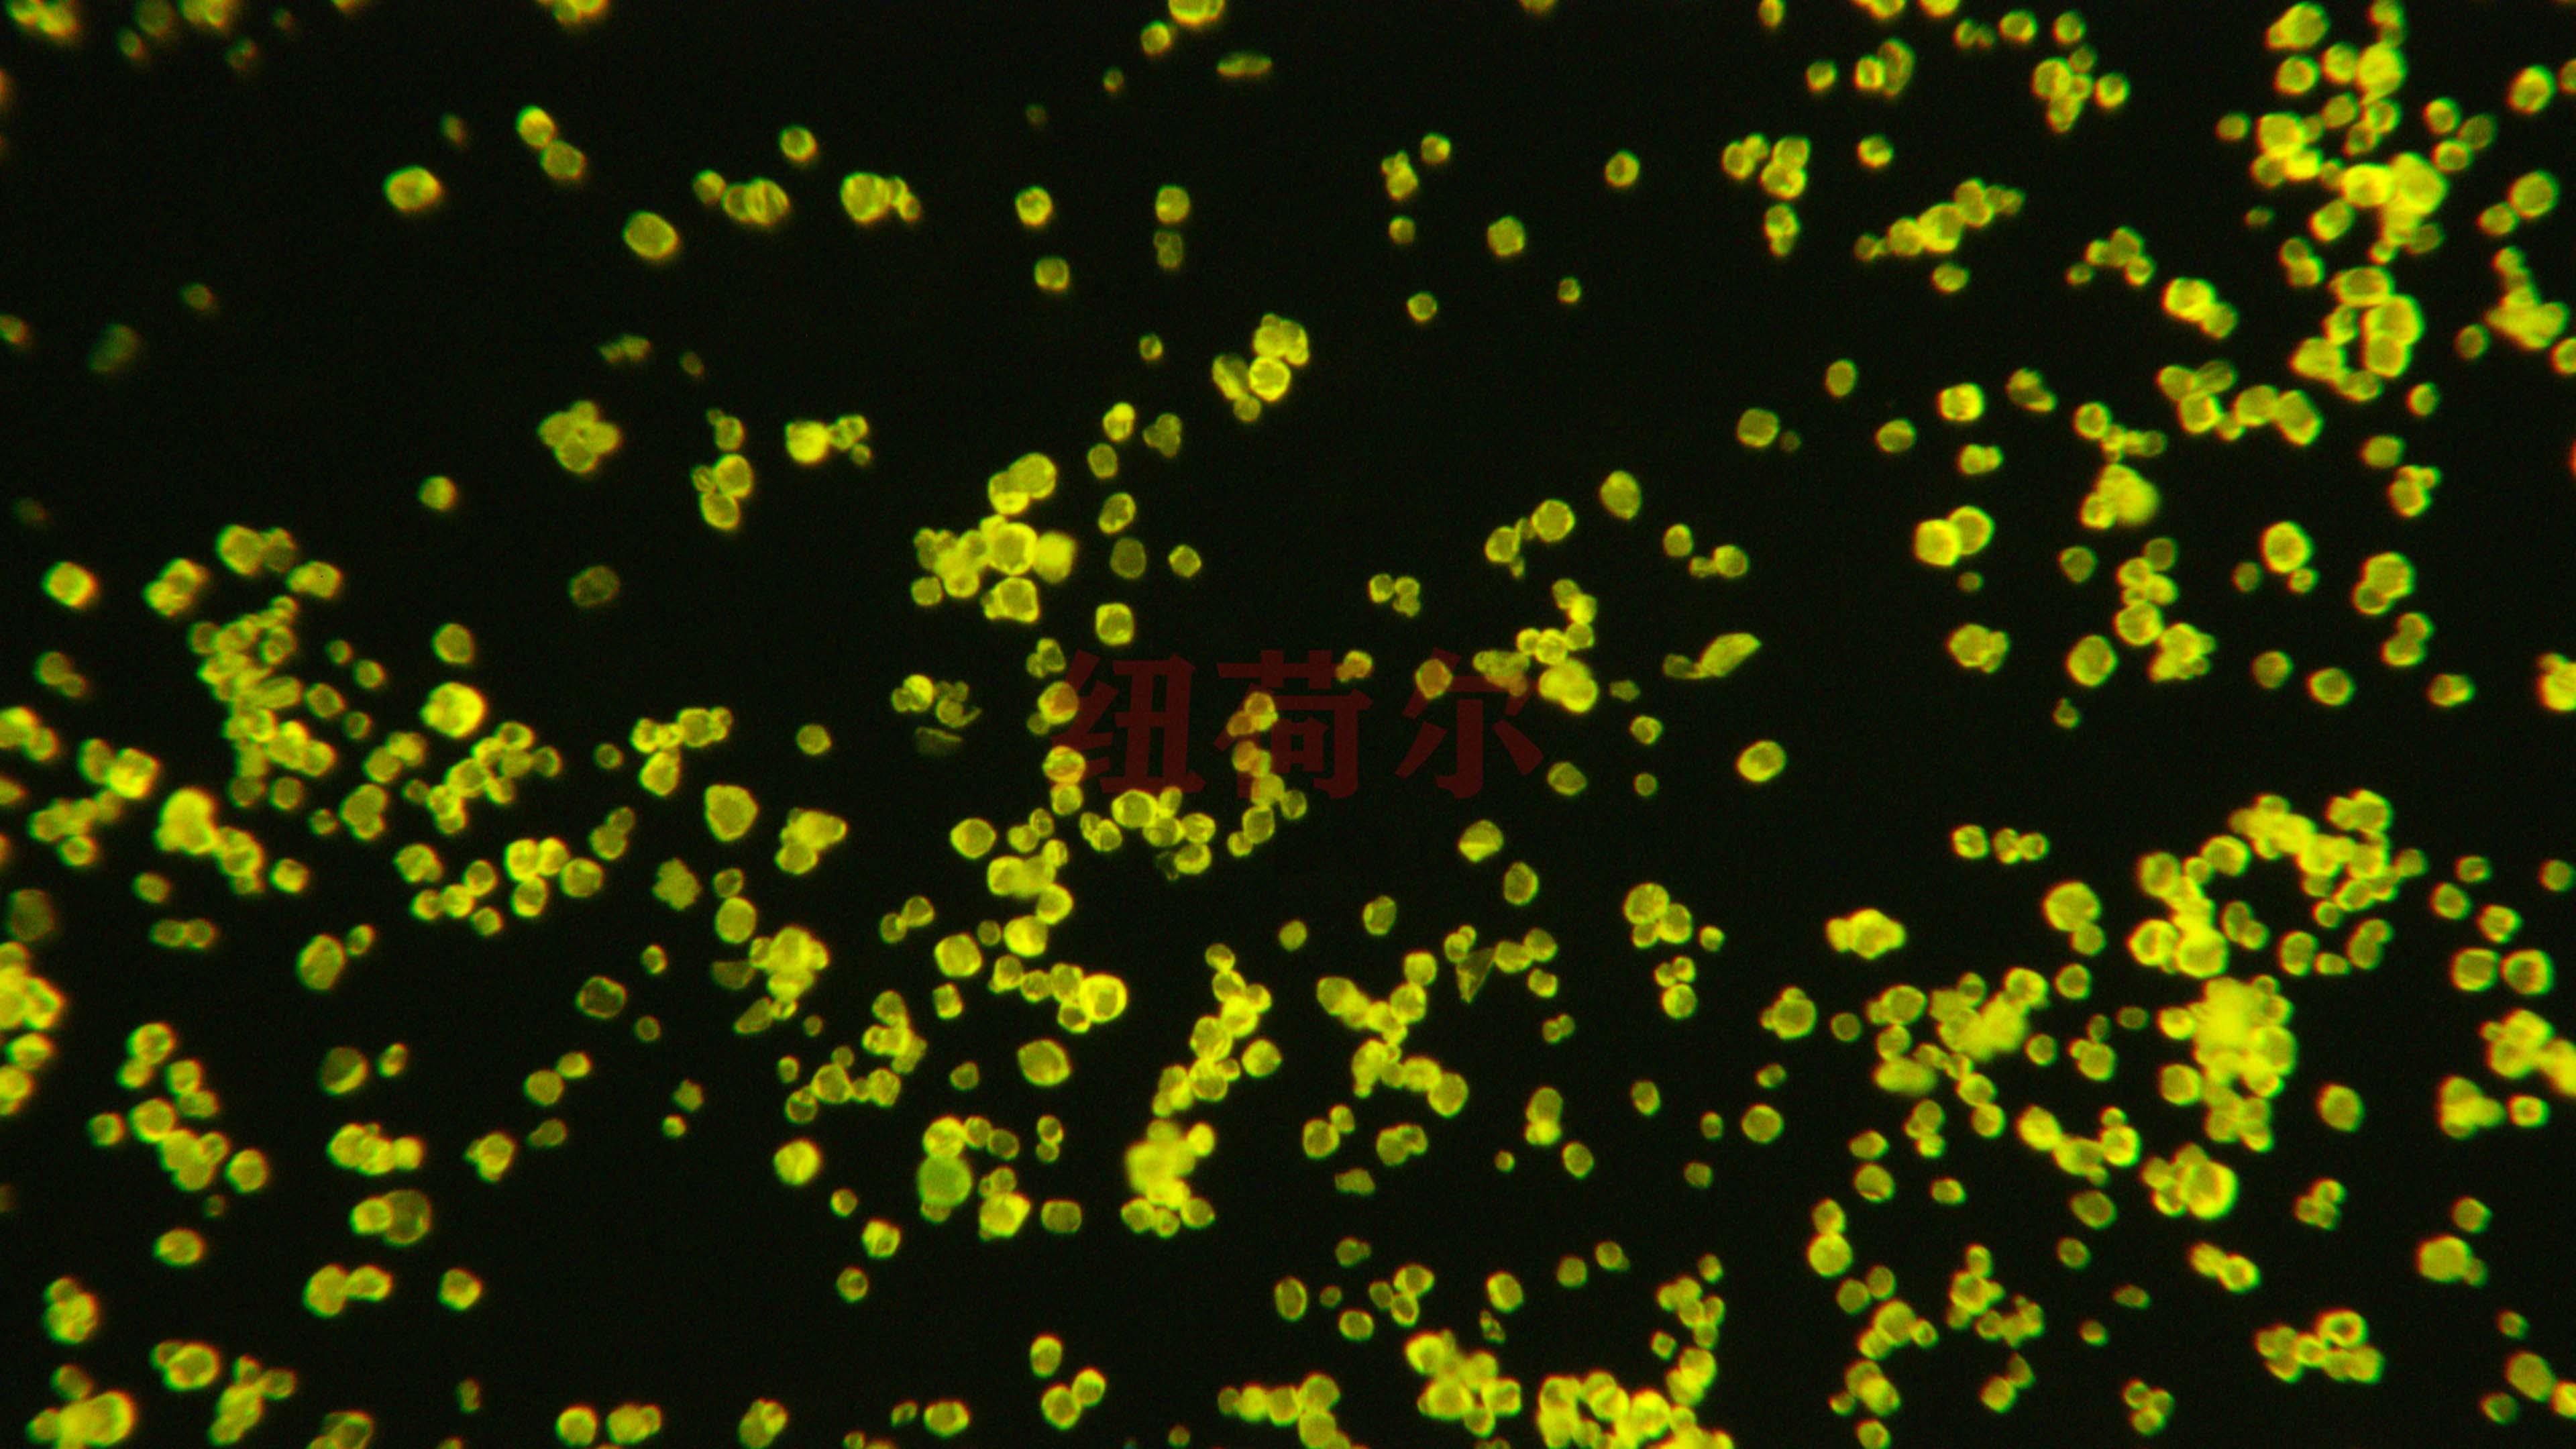

植发手术是一种主要用于治疗脱发和稀疏头发问题的医学方法。纽荷尔1000倍显微镜镀层观察,近年来,植发手术受到越来越多人的关注和需求。因此,植发医院的运营管理思路变得至关重要。本文将讨论植发医院的运营管理思路,包括市场定位、团队建设、服务质量和时间管理等方面。
植发医院的市场定位是成功运营的基础。首先,植发医院应该明确定位自己的目标人群,例如中年以上的男性或女性。其次,植发医院应该了解竞争对手的优势,并找到自己的差异化竞争策略。比如,提供创新和高质量的植发手术技术,以及个性化的服务体验。
植发医院的团队建设是运营管理中不可忽视的一环。植发手术需要高水平的医护团队来完成,因此,植发医院应该拥有一支具备专业知识和技能的团队。医生和技术人员应该接受专业培训和持续教育,以保持自身的竞争力和植发技术的先进性。此外,植发医院还应该重视团队的协作能力和良好的沟通,以提高工作效率和患者满意度。纽荷尔1000倍显微镜镀层观察。

服务质量是植发医院运营管理的核心。一流的服务质量可以帮助植发医院留住现有患者并吸引更多新患者。为了提供优质的服务,植发医院应该重视以下几点: - 给予患者个性化的咨询和指导,确保他们能够理解植发手术的过程和效果。 - 提供舒适和温馨的就诊环境,让患者感到放松和安心。 - 优化患者预约和就诊流程,减少等待时间,提高就医效率。 - 关注患者的售后服务,提供定期的随访和咨询,确保患者术后康复和效果满意。 - 建立患者满意度调查机制,及时了解患者需求和反馈信息,以持续改进服务质量。
植发医院的时间管理也是重要的一环。植发手术通常需要一定的手术时间和康复期。为了提高手术效率和预约管理,植发医院可以考虑以下几个方面: - 合理安排手术间的使用时间,避免时间冲突和浪费。 - 提前安排患者的术前准备工作和术后恢复指导,以减少手术耗时和提高患者的康复效果。 - 优化预约系统,确保患者能够方便地预约手术时间,并且合理安排手术医生的时间,以保证患者的需求得到满足。

植发医院的运营管理思路直接关系到医院的发展和患者的满意度。通过明确市场定位、团队建设、服务质量和时间管理等方面的策略,植发医院可以提高自身竞争力,为患者提供优质的植发服务。纽荷尔1000倍显微镜镀层观察,同时,植发医院还应关注市场动态的变化,并及时调整运营管理策略,以适应不断变化的植发市场需求。
我们拥有的3D形状扫描测量显微镜,为全球客户提高质量、效率和生产率。
© 版权所有 深圳纽荷尔科技有限公司
您要复制的内容
采购电话
联系任一团队,我们很乐意为您提供指导
更多经销商中心提供最新的营销和销售支持材料。
扫码关注微信 了解更多资讯
常见问题
网站链接
新闻资讯
最新活动
客户评价
产品资料
政策资质
关于我们
工作机会